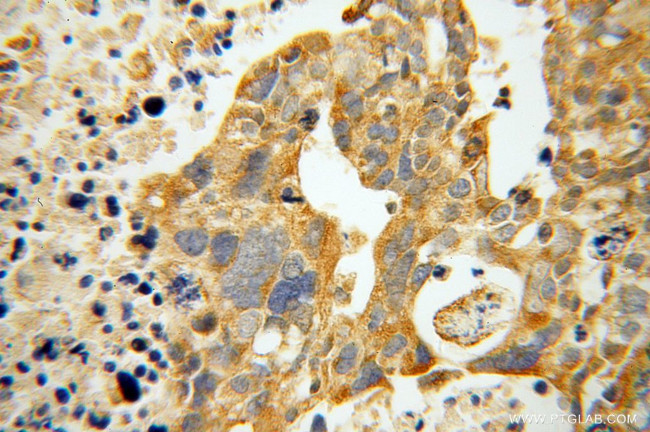
ATP11B Antibody in Immunohistochemistry (Paraffin) (IHC (P))

Search
Proteintech
ATP11B Polyclonal Antibody
{{$productOrderCtrl.translations['antibody.pdp.commerceCard.promotion.promotions']}}
{{$productOrderCtrl.translations['antibody.pdp.commerceCard.promotion.viewpromo']}}
{{$productOrderCtrl.translations['antibody.pdp.commerceCard.promotion.promocode']}}: {{promo.promoCode}} {{promo.promoTitle}} {{promo.promoDescription}}. {{$productOrderCtrl.translations['antibody.pdp.commerceCard.promotion.learnmore']}}
产品信息
13672-1-AP
种属反应
已发表种属
宿主/亚型
分类
类型
抗原
偶联物
形式
浓度
规格
纯化类型
保存液
内含物
保存条件
运输条件
产品详细信息
Immunogen sequence: SSGSAWFAI ILMVVTCLFL DIIKKVFDRH LHPTSTEKAQ LTETNAGIKC LDSMCCFPEG EAACASVGRM LERVIGRCSP THISRCEISL SSLCCR (10-104 aa encoded by BC033880)
靶标信息
ATP11B is a widely expressed integral membrane ATPase and is thought to drive the transport of phospholipids across membranes. It has been suggested that ATP11B is hormonally regulated and plays a role in the subnuclear trafficking of transcription factors with RING motifs. While the exact molecule ATP11B transports is unknown, increased mRNA expression of the homologous ATP11A has been observed in cells resistant to anti-cancer drugs such as farnesyltransferase inhibitors (FTIs), suggesting that ATP11B may also play a role in cell survival under harsh conditions.
仅用于科研。不用于诊断过程。未经明确授权不得转售。
生物信息学
蛋白别名: ATPase Class VI type 11B; ATPase IR; ATPase, class VI, type 11B; P4-ATPase flippase complex alpha subunit ATP11B; Phospholipid-transporting ATPase IF; probable phospholipid-transporting ATPase IF; TIEG; TIEG1; unnamed protein product
基因别名: 1110019I14Rik; ATP11B; ATPIF; ATPIR; KIAA0956; mKIAA0956
UniProt ID: (Human) Q9Y2G3, (Mouse) Q6DFW5
Entrez Gene ID: (Human) 23200, (Rat) 361929, (Mouse) 76295